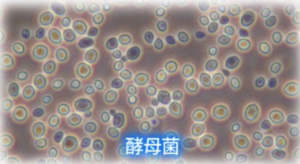

皆様、こんにちは!
OK-DEPOTです。
![]()
最近・・・こういう質問をよくいただきます!
EM珪藻土やEM漆喰の「EMってなに?」

![]()
そんな質問に答えていきます!![]()
「EM」ってなんだか難しそうなアルファベットですが
実は私たちの生活や地球環境を良くしてくれる「目に見えない小さなヒーローたち」のことなんです。

![]()
今回は、最近エコな暮らしや家庭菜園で注目を集めている
「EM(有用微生物群)」について
誰にでもわかるようにやさしく解説します!
![]()
EM(イーエム)ってそもそも何?
![]()
![]()
EMとは、「Effective Microorganisms(エフェクティブ・マイクロオーガニズムス)」の頭文字をとった言葉で日本語では「有用微生物群(ゆうようびせいぶつぐん)」と呼ばれています。
![]()
簡単に言うと
「自然界にいる、人間や環境にとって良い働きをしてくれる菌を集めたチーム」のことです。
特定の1つの菌の名前ではなく
複数の良い菌が協力し合っているのが特徴です。
![]()
![]()
チームEMの主要メンバー
![]()
![]()
EMの中にはたくさんの菌がいますが
代表的なのは私たちが普段から食べているものにも含まれている、とても身近な菌たちです。
![]()
![]()
![]()
-
乳酸菌(にゅうさんきん)
ヨーグルトやチーズでおなじみ。悪い菌が増えるのを防ぎ、腐敗(腐ること)を抑えてくれます。
![]()

![]()
![]()
-
酵母菌(こうぼきん)
パンやビールを作る時に大活躍。
アミノ酸やビタミンなど、植物や他の菌の栄養となるものを作り出します。
![]()
![]()
-
光合成細菌(こうごうせいさいきん)
EMの要となる菌です。
悪臭の原因になる有害な物質をエサにして、役に立つ物質に変えてくれます。
![]()
![]()

これらが一緒になることで、お互いを助け合い、素晴らしいパワーを発揮するのです!
![]()
![]()
EMは私たちの暮らしでどう役立つの?
![]()
![]()
「良い菌なのはわかったけれど、具体的にどう使うの?」と思いますよね。
実は、EMは毎日の暮らしのいろんな場面で大活躍します。
![]()
![]()
1. 【ガーデニング・家庭菜園】ふかふかの土を作る
![]()
![]()
EMを薄めた水(EM活性液)を土にまくと、土の中の良い微生物が増えます。
すると、土がふかふかになり、野菜やお花が病気になりにくく、元気に美味しく育ちます。
無農薬や有機栽培に挑戦したい方にぴったりです。
![]()
2. 【お掃除・消臭】安全にピカピカ&ニオイすっきり
![]()
EMは「腐敗(悪臭の原因)」を抑えて「発酵」を進める力があります。
そのため、薄めたEM液をスプレーボトルに入れ
トイレや生ごみ、ペットのトイレ周りにシュッと吹きかけると
嫌なニオイを元から断ってくれます。
化学物質が入っていないので
小さなお子様やペットがいるご家庭でも安心です。
![]()
3. 【生ごみ処理】ゴミを減らして肥料に変える ♻️
![]()
「EMボカシ」というアイテムを使うと
家庭の生ごみを嫌なニオイを出さずに発酵させ
栄養満点の肥料に変えることができます。
ゴミの量が減ってエコですし
できた肥料で美味しい野菜が作れるという一石二鳥のアイデアです!
![]()
そのような有用な「EM」を弊社は建材にも取り入れており
自然素材100%を実現しております。
ご興味ありましたら、ぜひお問合せください。
![]()
![]()